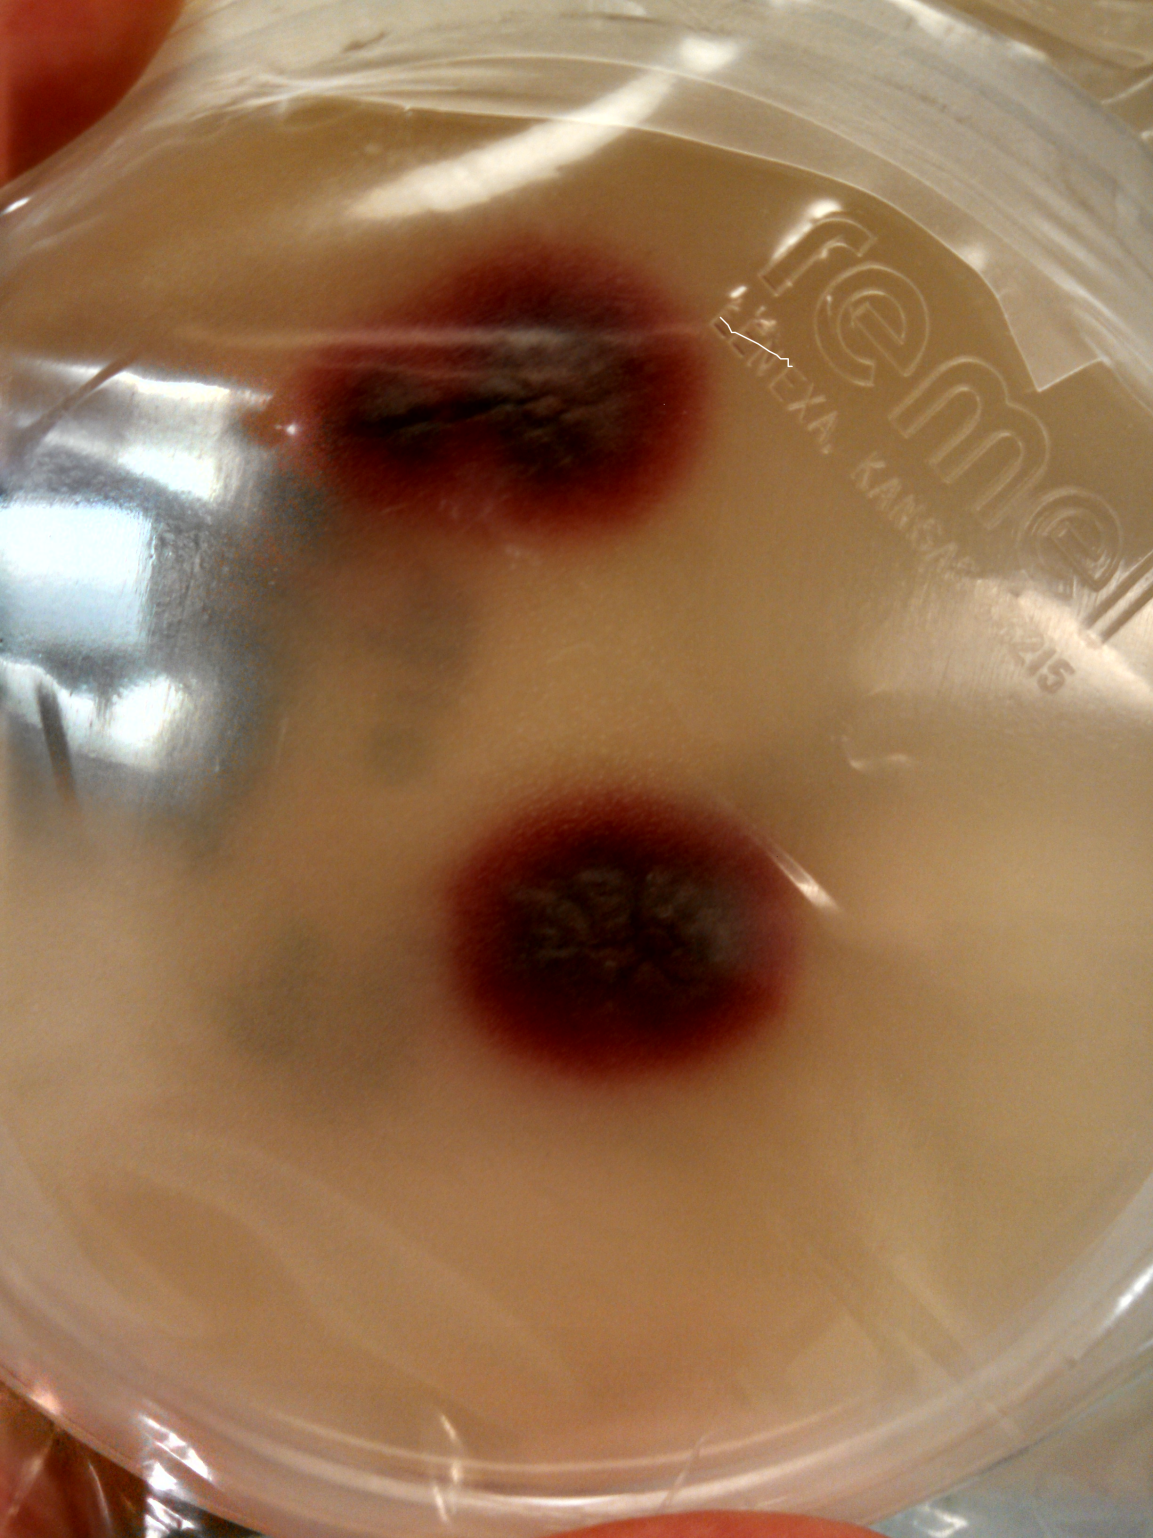

Case:
A 5 year old boy who recently immigrated to the United States from Africa presented to his primary care physician with several rough, hypopigmented skin lesions and some hair loss on the scalp. The rash was treated with topical antifungal medication. The patient was treated with griseofulvin for tinea capitis and initially responded well. Six months later he developed pruritic macules on his body, for which clotrimazole was prescribed. The patient’s scalp at that time showed few lesions concerning for recalcitrant tinea capitis. He was prescribed weekly fluconazole and topical clotrimazole. Fungal cultures grew an organism with the following scotch tape prep and colony morphology.

Laboratory identification:
The scotch tape prep showed branched, tortuous hyphae and chlamydoconidia in chains but no microconidia or macroconidia were present. The colonies took over two weeks to grow and were initially cream-colored but later developed a port wine to deep violet color. Based on this information Trichophyton violaceum, Trichophyton rubrum, and Trichophyton soudanense were on the differential diagnosis. The specimen was sent to a referral lab for definitive speciation. The referral lab identified the organism as Trichophyton violaceum by MALDI-ToF. The organism was also sequenced for confirmation.
Discussion:
Trichophyton violaceum is a dermatophyte that can be recovered from hair, skin, and nails. The organism requires 14-18 days to grow. Its growth is enhanced by media containing thiamine, which helps differentiate it from other species within the Trichophyton genus. Infection typically causes “black dot” tinea capitis, tinea corporis, and onychomycosis. Infections with this particular Trichophyton species are seen primarily in persons living in Mediterranean region, the Middle East, and Africa. It is treated with oral griseofulvin.
-Lauren Pearson, D.O. is a 2nd year anatomic and clinical pathology resident at the University of Vermont Medical Center.
-Christi Wojewoda, MD, is the Director of Clinical Microbiology at the University of Vermont Medical Center and an Assistant Professor at the University of Vermont.
